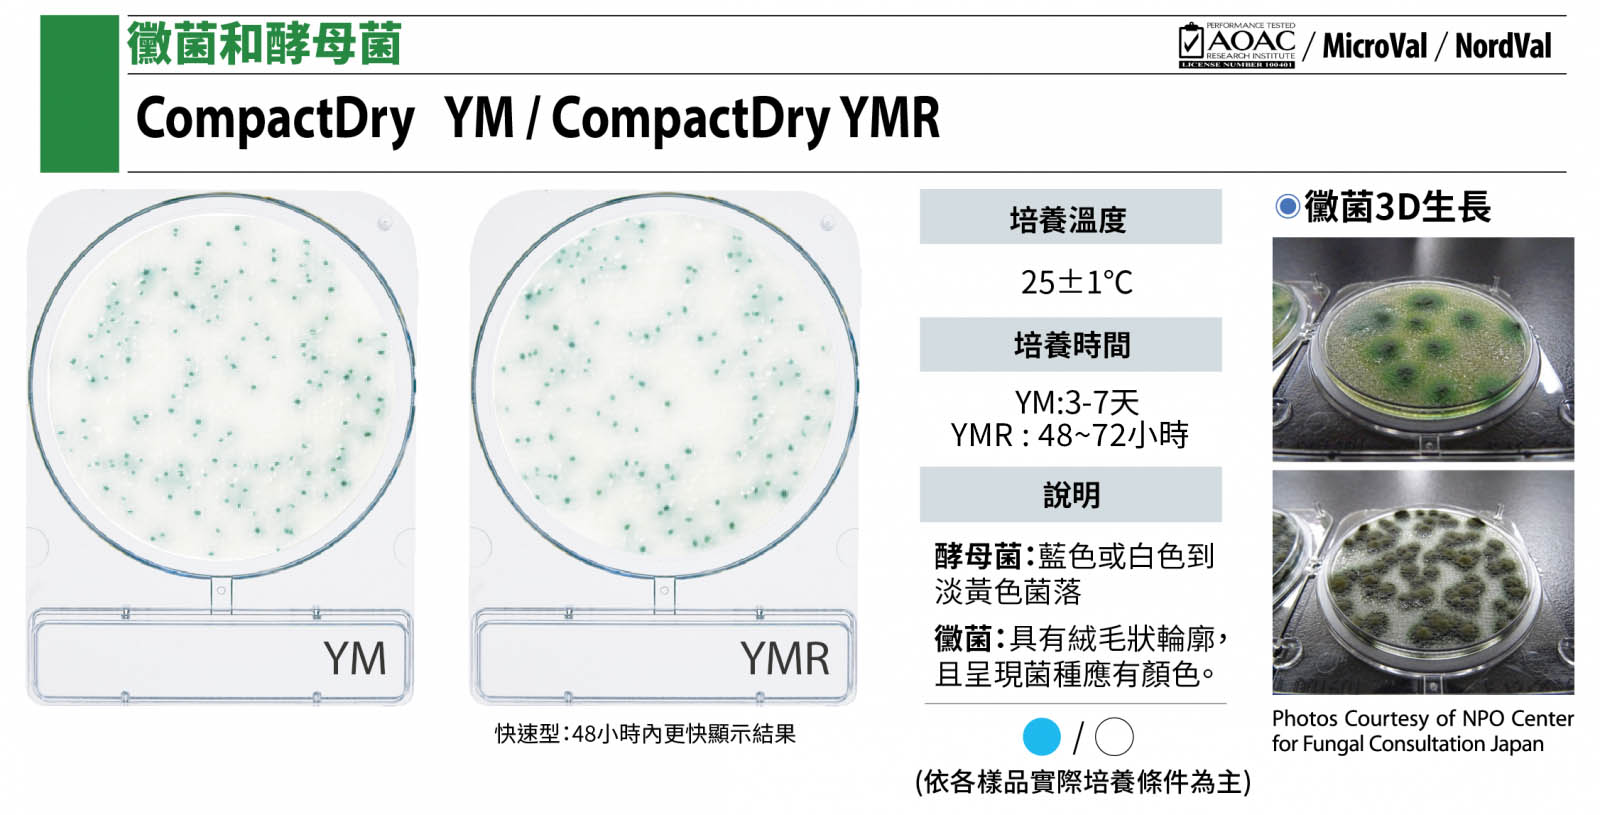
Compact Dry YM / YMR 黴菌/酵母菌測試片(普通版 / 快速板)

●乾式培養基,可放常溫保存
●特殊呈色基質,易於判讀
●三大國際認證,品質穩定有保證
●輕巧方便、節省培養空間
●產品線齊全,把關檢測守門員
價格 : 請洽詢 (02)2697-3338
微生物快速檢驗測試片 - 乾式薄膜快檢片

Total Count Rapid / Aerobic Plate Count Rapid
總生菌數的檢驗為食品檢驗的指標之一,是判斷食品加工過程衛生與否及食物新鮮程度的重要依據,食品在製作過程中滋生過量微生物,則代表不夠新鮮。Compact Dry TCR 快速總生菌數測試片含有2,3,5-Triphenyl Tetrazolium Chloride(TTC)成分,是一種氧化還原的指示劑,可與大部分增殖生長的菌落產生紅色顯色反應。
●培養溫度: 35±1℃ (依各樣品實際培養條件為主)
●培養時間: 24±2hr
●菌落判讀: 紅色菌落數+白色菌落數
Total Viable Count / Total Count / Aerobic Plate Count
總生菌數的檢驗為食品檢驗的指標之一,是判斷食品加工過程衛生與否及食物新鮮程度的重要依據,食品在製作過程中滋生過量微生物,則代表不夠新鮮。Compact Dry TC 總生菌數測試片含有2,3,5-Triphenyl Tetrazolium Chloride(TTC)成分,是一種氧化還原的指示劑,可與大部分增殖生長的菌落產生紅色顯色反應。
●培養溫度: 35±1℃ (依各樣品實際培養條件為主)
●培養時間: 48±3小時
●菌落判讀: 紅色菌落數+白色菌落數
Escherichia coli and Coliform, EC
大腸桿菌是人類和其他恆溫動物腸道中的正常菌種,所以食品一旦出現大腸桿菌,即意味著食品可能直接或間接的被糞便污染。因此在衛生學上,常被當做食品的衛生檢定指標。Compact Dry EC 大腸桿菌/大腸桿菌群測試片中含有MAGENTA-GAL及X-GLU兩種酵素呈色物質,與大腸桿菌會形成藍~藍紫色的的菌落;與大腸桿菌群則會形成粉色~紫紅色的菌落。
●培養溫度: 37±1℃
●培養時間: 24±2小時
●菌落判讀: 大腸桿菌為藍~藍綠色的的菌落 / 大腸桿菌群為粉紅色~紫紅色菌落
Coliform, CF
Compact Dry CF 大腸桿菌群快檢片操作過程中不須壓版,其獨特立體纖維材質在接種後,會自動向外擴散且不滲漏,不僅操作方便省時,內建的網格可有效簡化計數程序,且體積更小於一般培養皿,可無限次疊加。Compact Dry CF 大腸桿菌群測試片通過AOAC認證與歐洲NordVal、Microval國際檢驗認證單位認證。
●培養溫度: 37±1℃ (依各樣品實際培養條件為主)
●培養時間: 24±2小時
●菌落判讀: 大腸桿菌群呈現會形成藍~藍綠色的的菌落
Coliform(Rapid type),CFR
Compact Dry CFR 大腸桿菌群快檢片操作過程中不須壓版,其獨特立體纖維材質在接種後,會自動向外擴散且不滲漏。不僅操作方便省時,更能在培養6至16小時後以紫外光進行快速判讀。內建的網格可有效簡化計數程序,且體積更小於一般培養皿,可無限次疊加。
●培養溫度: 35±1℃
●培養時間: 6~16小時(快速偵測),16~18小時(快速確認)
●菌落判讀: 大腸桿菌群呈現會形成藍~藍綠色的的菌落
Staphylococcus aureus
金黃色葡萄球菌是一種常見的細菌,普遍存在於人體的鼻腔、咽喉和皮膚。含菌的食物如果保存不當,病菌便大量孳生且產生毒素,因此是食物中毒的主要致病原因之一。Compact Dry XSA 金黃色葡萄球菌測試片中含有酵素呈色物質,會使金黃色葡萄球菌生長形成藍色扎實的菌落。
●培養溫度: 37±1℃
●培養時間: 24±2小時
●菌落判讀: 金黃色葡萄球菌為藍色扎實的菌落
Compact Dry BC仙人掌桿菌測試片
Bacillus cereus
仙人掌桿菌因周身佈滿短鞭毛,如同仙人掌因而得名。在環境中分布廣泛,極易由灰塵及昆蟲傳播污染食品,Compact Dry BC仙人掌桿菌測試片含有特殊呈色酵素物質可與大部分仙人掌菌落產生藍色~綠色顯色反應。
●培養溫度: 30±1℃
●培養時間: 24±2小時
●菌落判讀: 仙人掌桿菌為藍色~綠色菌落
Salmonella species
沙門氏菌感染症為食入性的感染疾病,亦為人畜共通傳染疾病,主要因食入遭受動物糞便污染的食物而感染。Compact Dry SL 沙門氏菌測試片培養基中含有 Lysine,而Salmonella 含有Lysine decarboxylase 可使培養基鹼性化,可使培養基變黃(原為藍紫色)
●增殖培養: 36±1℃ 培養 22±2小時
●培養溫度: 41.5±2℃
●培養時間: 22±2小時
●測試片判讀: 陰性: 紫色~藍紫色 陽性: 黃色
●顏色反應: 黃色:移動性反應 (必要) 黑色:硫化氫反應 (偶發) 綠色:聚集酵素反應 (偶發)
Enterobacteriaceae,ETB
腸桿菌又稱腸內菌,分類上為革蘭氏陰性菌、兼性厭氧及呈棒狀的細菌,除了大腸桿菌群包含的乳糖發酵型細菌外,還包含了許多非乳糖發酵型細菌 (如. 沙門氏菌、志賀氏菌、變形桿菌…等)。腸桿菌科菌落會形成紅/紅紫色,而其他菌落則會形成白色或黃色。
●培養溫度: 37±1℃
●培養時間: 24±2小時
●菌落判讀: 腸桿菌科呈現紅色~紫紅色菌落
Vibrio parahaemolyticus, VP
腸炎弧菌所引起的食品中毒,最早於1950 年發生於日本。因為本菌會製造三種以上的溶血物質,所以又稱為副溶血性弧菌。Compact Dry VP 腸炎弧菌測試片培養基中含有酵素呈色物質,當腸炎弧菌在此培養基上生長時,會出現藍色顯色反應。創傷弧菌、霍亂弧菌、擬態弧菌在此培養基上將會形成淡粉紅色~紫紅色的菌落。
●培養溫度: 35±1℃
●培養時間: 19±1小時
●菌落判讀: 腸炎弧菌呈現藍色~藍綠色菌落,霍亂或創傷弧菌呈現粉色~紅色菌落,溶藻弧菌呈現白色菌落
Compact Dry YM / YMR 黴菌/酵母菌測試片(普通版 / 快速版)
Yeast and Mold / Yeast and Mold Rapid detection(快速板)
黴菌和酵母菌廣泛分布於自然界,也是食品和環境正常菌相的一部分。在某些情況下,黴菌和酵母可能造成食品腐敗變質。由於黴菌及酵母菌能抵抗冷凍,抗生素、輻照等,進而促進致病細菌的生長而產生有毒代謝產物-黴菌毒素。Compact Dry YM / YMR 黴菌/酵母菌測試片含有發色酵素基質X-Phos使大部分酵母菌呈現藍色或乳白色,黴菌則呈棉絮狀的菌落與其自身特性所帶有的顏色。
●培養溫度: 25±1℃
●培養時間: YM3-7天、YMR(快速版) 48~72小時
●菌落判讀: 酵母菌呈現藍色或乳白色菌落,黴菌菌落大多具有絨毛狀輪廓,且呈現菌種應有顏色。
Compact Dry LM 單核球增多性李斯特菌乾式測試片
Listeria monocytogenes,LM
衛福部食藥署公告方法中翻譯為單核球增多性李斯特菌,也有翻譯為單核細胞增生李斯特氏菌或單核球李斯特菌,為兼性厭氧(facultative anaerobe)之革蘭氏陽性桿菌,對環境適應性強,可存活於多種不同的環境條件,於4℃條件下可持續生長繁殖,且對於乾燥、高溫、酸性環境、鹽及酒精具耐受性(需達72°C以上才可殺死),因此,人類如生食蔬果或未經充分加熱的即食性食品,都可能感染李斯特菌。
●增殖培養: 30±1℃ 培養 25±1小時
●試片培養: 37±1℃ 培養 24±2小時(可拉長額外的24±2小時)
●菌落判讀: 單核球增多性李斯特菌會呈現淡藍色光暈環繞的紅色菌落
Listeria species,LS
李斯特菌對環境適應性強,廣泛存於自然界中,常發現於土壤、腐生植物和許多哺乳動物的糞便中,為人畜共通傳染病源之一。雖然李斯特菌中毒事件並不多見,但死亡率卻高達30~35%。Compact Dry LS 李斯特菌測試片培養基中所含的色原體而形成直徑為1-2mm的淡藍色/藍色菌落。
●增殖培養: 30℃ 培養 24±2小時
●試片培養: 35±1℃ 培養 24±2小時 ~ 48±3小時 (依各樣品實際培養條件為主)
●菌落判讀: 李斯特菌呈現淡藍色~藍色菌落
Pseudomonas aeruginosa,PA
綠膿桿菌屬革蘭氏陰性菌,最適合生長溫度為25~37 ℃,故可生長在人體內,綠膿桿菌容易經水作為媒介傳染至人體死亡率高達 70%,高於其他常見的伺機性感染細菌。Compact Dry PA 綠膿桿菌測試片特殊酵素呈色物質,使綠膿桿菌會形成紅色菌落,通常其菌落外環會形成黃綠色。在液體樣品中使用濾膜法,其菌落將會是綠膿桿菌本身帶有的綠色。
●培養溫度: 36±1℃
●培養時間: 48±3小時
●菌落判讀: 綠膿桿菌會呈現淡黃綠色光暈環繞的紅色菌落,濾膜法綠膿桿菌則呈現綠膿桿菌本身帶有的淺綠~綠色菌落
Compact Dry AQ 水質總生菌(異營菌)乾式測試片
Water Heterotrophic bacteria,AQ
水的乾淨與否是一個重要的環境指標,水中微生物分析可以了解當中的細菌族群及數量,水質總生菌做為環境研究的基礎,甚至進一步得知人為汙染的情況。Compact Dry AQ 水質總生菌(異營菌)乾式測試片培養基中的氧化還原系統中含有四氮唑鹽,增殖的大部分菌落發生紅色顯色反應。
●培養溫度: 36±2℃ / 22±2℃(ISO6222) / 濾膜法 35±1℃
●培養時間: 44±4小時 / 68±4小時(ISO6222) / 濾膜法 48±2小時
●菌落判讀: 水質異營菌大部分呈現紅色,酵母菌則為亮粉紅色,黴菌呈現為立體棉絮狀
Enterococcus species,ETC
糞腸球菌及屎腸球菌為腸球菌屬(Enterococcus)的主要菌種之一,過去曾被歸類為益生菌,水質檢測的糞便性鏈球菌亦屬於腸球菌的一種,惟世界衛生組織聯合工作小組(WHO Working Group)重新評估後,基於腸球菌菌株具有萬古黴素之抗藥性,且部分具有抗萬古黴素抗藥性基因之腸球菌菌株與醫院院內感染相關,因此不建議再將腸球菌作為益生菌供人類使用。Compact Dry ETC 腸球菌測試片培養基中含有X-Gluc與抗生素作為選擇媒介,會形成藍~藍綠色的的菌落。
●培養溫度: 37±1℃
●培養時間: 20~24小時
●菌落判讀: 腸球菌大部分呈現會形成藍~藍綠色的的菌落
Escherichia coli, EC
大腸桿菌檢片操作過程中不須壓版,其獨特立體纖維材質在接種後,會自動向外擴散且不滲漏,不僅操作方便省時,內建的網格可有效簡化計數程序,且體積更小於一般培養皿,可無限次疊加。Compact Dry EC 大腸桿菌/大腸桿菌群快檢片於日本製造,符合ISO9001 / ISO13485 / ISO14001規範,品質製程安心又可靠。
●培養溫度: 37±1℃ (依各樣品實際培養條件為主)
●培養時間: 24±2小時
●菌落判讀: 大腸桿菌大部分呈現菌會形成藍~藍綠色的菌落
微生物培養基 - Culture Media - 請點下圖▼
Food / Clean Stamp 表面採樣微生物檢測片 - 請點下圖▼
EC BLUE 水質酵素螢光檢測套組 - 請點下圖▼
微生物鑑定 - 微生物菌種鑑定套組 - 請點下圖▼
微生物序列稀釋套組 - 請點下圖▼









.png)


.png)

.png)